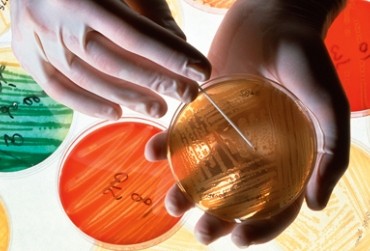

Ludzie, których spotkałam podróżując po Nepalu, Serbii i Gruzji, promieniowali szczęściem. Nie wiedzieli, na czym polega profilaktyka zdrowotna, ale zawsze byli uśmiechnięci. Nie martwili się na zapas, przyjmowali to, co przyniósł los.
Autor: Anna Kołodziejska
Jeszcze do niedawna wydawało się, że wraz z postępem medycyny będziemy żyć dłużej. Dziś badacze alarmują, że czas naszego życia skróci się, bo… za mało się ruszamy. Jak odwrócić ten trend?
Czujesz ostatnio lęk, tyjesz i trudno ci się skupić na pracy? Być może to efekt... nieodpowiedniego składu mikroflory jelitowej. Jakich bakterii potrzebujemy i gdzie je znaleźć?
Lekarze alarmują: wkrótce staniemy się bezsilni w walce z bakteriami, z którymi do tej pory bez trudu wygrywaliśmy. Dzieje się tak dlatego, że nadużywamy antybiotyków i jemy nafaszerowane nimi mięso.
Czujesz ostatnio lęk, tyjesz i trudno ci się skupić na pracy? Być może to efekt... nieodpowiedniego składu mikroflory jelitowej. Jakich bakterii potrzebujemy i gdzie je znaleźć?
Jak sobie pościelesz, tak się wyśpisz – brzmi znane przysłowie. Rzeczywiście, na jakość naszego snu istotny wpływ mają kołdra, poduszka, pościel czy rodzaj materaca. Często to do nich dostosowujemy naszą pozycję we śnie, a ta ma wpływ na to, czy śpimy zdrowo.
Nie zawsze wystarczy się położyć, aby zasnąć. Przespana noc to czasem zbyt mało, aby rano obudzić się w pełni sił. I nawet wstając o poranku wyspanym, nie można mieć pewności, że sen był dla ciała dobry i zdrowy.
Ludzie, których spotkałam podróżując po Nepalu, Serbii i Gruzji, promieniowali szczęściem. Nie wiedzieli, na czym polega profilaktyka zdrowotna, ale zawsze byli uśmiechnięci. Nie martwili się na zapas, przyjmowali to, co przyniósł los.
Na szlak ruszyliśmy, gdy „góry wyszły”. Na tle czystego po burzy nieba malował się ośnieżony szczyt – Machhapuchhre. Staliśmy jak zaczarowani, wydawało nam się, że od góry dzieli nas tylko kilka kroków.
Lato to świetny czas na wzmocnienie odporności. Co jeść i o jakie nawyki zadbać teraz, by bez kataru i gorączki przetrwać zimę?
Każdy powinien codziennie przyjmować witaminę D! Witamina C wyleczy nawet raka! – zachwalają producenci suplementów. Co jest prawdą, a co mitem? Komu i kiedy potrzebna jest dodatkowa dawka witamin?